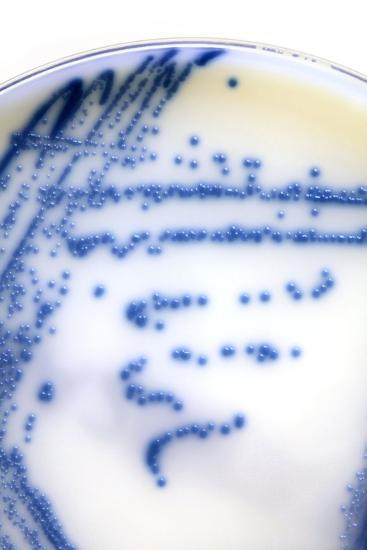
Photographic Print, , large

MRSA Bacteria In a Petri Dish Photo Print
Choose size
Finished Size: 12" x 18"

Just the Print
$27

Essential Black
$59

Chelsea Black
$116

Soho Thin Espresso
$116

Stretched Canvas

Framed Canvas

Wood Mount
$86

Laminate
$52

Just the Print

Black Frame

White Frame

Brown Frame

Stretched Canvas
$89

Canvas Black
$149

Wood Mount

Laminate

Just the Print
$32

Chelsea Black
$269

Chelsea White
$269

Soho Thin Espresso
$269

Stretched Canvas
$89

Canvas Black
$149

Wood Mount
$122

Laminate
$57

Just the Print
$38

Gramercy Black
$275

Gramercy White
$275

Gramercy Espresso
$275

Stretched Canvas
$159

Canvas Black
$219

Wood Mount
$140

Laminate
$63
see more frame options
$27
Arrives by Sat, Feb 14 to 66952

$27
12" x 18" - Photographic Print
12" x 18" - Photographic Print


